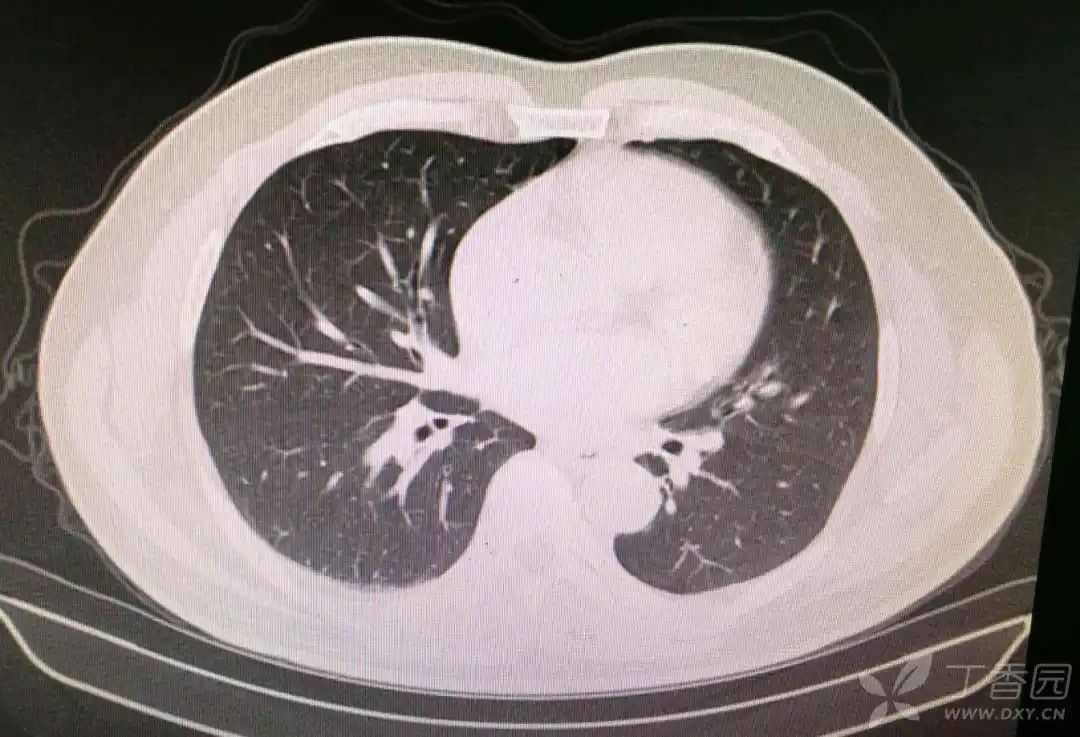
张力减低,双下肢腱反射减弱,脐平面以下针刺觉减退,双侧病理征未引出

病理征

病理反射ppt
图片尺寸800x600
病理生理学
图片尺寸1713x2495
病理反射 几种病理反射的检查方法
图片尺寸1080x810
求助各位战友一个病例(病理结果已公布)
图片尺寸640x431
异常,右侧肢体肌力5级,左侧肢体肌力4级,双侧痛觉对称,左侧病理征阳
图片尺寸1590x1029
无忧文档 所有分类 医药卫生 基础医学 神经反射检查ppt (三)病理反射
图片尺寸1080x810
张力低,双下肢膝反射消失,脐以下浅感觉减退,深感觉正常,双侧病理征阴
图片尺寸4032x2268
肺部影像学之病理征王忠平医学9787558741159
图片尺寸800x800
【病理】
图片尺寸944x394
人生最后一顿鲍鱼
图片尺寸1597x780
世界卒中日后第三天安利公众一个词醒后卒中
图片尺寸520x375
人生最后一顿鲍鱼
图片尺寸1608x771
肺组织病理,可见隐球菌
图片尺寸550x546
张力减低,双下肢腱反射减弱,脐平面以下针刺觉减退,双侧病理征未引出
图片尺寸1080x737
12中山大学医学院精品课程病理生理学多器官功能不全综合征ppt
图片尺寸1080x810
肺水肿病理:肺泡壁毛细血管扩张淤血,肺泡腔内可见大量水肿液和心衰
图片尺寸750x452
诊断学病理征图片
图片尺寸1080x810
抑郁综合征是以病理性抑郁心境为主要表现,同时可伴随思维,行为症状的
图片尺寸3755x2047
图1 眼科,组织病理学检查结果;(a)裂隙灯检查可见角膜弓和角膜浑浊;(b
图片尺寸578x430
季节交替 卒中防治要加强
图片尺寸1668x1251